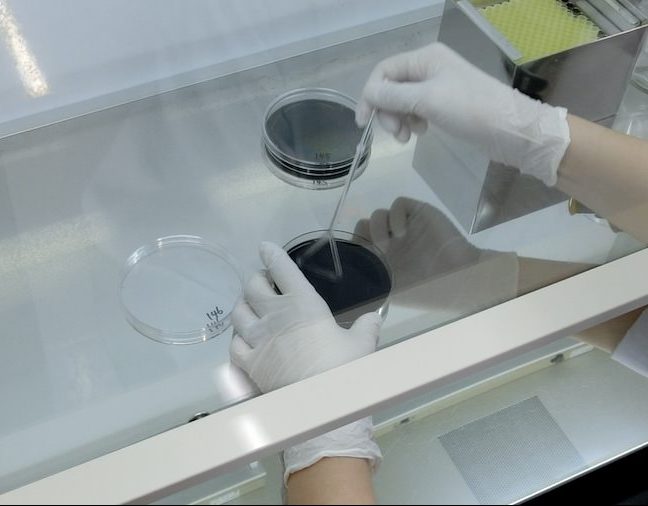
1106141301_690c2e5d839e6.jpg

ブログ
2019/06/05
【体験レポート】弊社社員が自宅のお水を水質検査してみました

目次
- A社員が気になっていたこと
- 今回検査したもの
- レジオネラ検査
- 13項目水質検査
- キット到着
- レジオネラ検査キットの容器
- 13項目検査キットの容器
- 自宅でお水を採取
- 検査結果
- レジオネラ検査結果
- 水道水検査結果(13項目検査結果)
- 検査を終えたA社員の感想
- まとめ
こんにちは、WEB担当です。
自宅のお水や店舗のお水の検査を検討している方から、『どうやってお水を採ればいいの?』、『検査はどうやってするの?』というお問い合わせを時々いただきます。はやり、はじめて検査を申し込もうとされている方は、どうしても戸惑ってしまうもの。
そこで、弊社社員に実際に水質検査キットで自宅のお水を検査してもらい、その様子をレポートします。水質検査をご検討の方の参考になればと思います。
※今回は自主検査で、「水道法」に基づく検査(専用水道設置者等の水道事業者様が自ら供給する水の検査=法定検査)ではありません。
A社員が気になっていたこと
今回検査したのはA社員の自宅の水。A社員が自宅の水について、どんなことが気になっていたか聞きたところ、赤ちゃんにとって安心できる水かどうか気になっている、とのこと。
A社員「子供が生まれたばかりなので、自宅の浴槽が赤ちゃんが安心して入れる環境にあるのかどうか調べたいです。あと、自宅の水道水が安心して飲めるお水か、とくに赤ちゃんのミルクやご飯を作るときに自宅の水道水が適したお水かどうか気になってます」
今回検査したもの
レジオネラ検査
お風呂の水にレジオネラがいないかどうか調べる検査です。実際に培養検査を行って検査します。どんな感じかというと、こんな感じ。
レジオネラ検査の説明
レジオネラ検査の様子
レジオネラ菌に感染してレジオネラ症を発症した場合の死亡率は15~30%。国内で毎年60名近くが亡くなっている危険な病原菌です。免疫力が低い高齢者や幼児はとくにレジオネラ肺炎を発症しやすいので、一般住宅のお風呂や超音波式の加湿器でも感染・発症事例が報告されています。
13項目水質検査
13項目水質検査は、井戸水などを調べるときによく行われる11項目セットに、『鉄』と『硬度』を追加したセットです。飲み水の味が気になる方や食品製造への硬度の影響を知りたいときによく使われるセットです。こんな感じで検査をします。
赤ちゃんのミルクを作るときに使う水は軟水が望ましいと言われています。硬度があまり高い硬水を使うと、その成分が過剰となり、必要量以上にミネラルを摂取してしまうためです。市販のミルクは赤ちゃんに理想的な栄養成分が調整されていて、ミネラルもミルクの中にあらかじめ含まれています。
キット到着
A社員が申し込みを済ませると、さっそく以下のキットが届きました(通常はキットが郵送で届きますが、今回はすぐ近くにいるので手渡しです)。
レジオネラ検査キットの容器
レジオネラ検査キットの中身は以下。
- レジオネラ・浴槽水検査 採水マニュアル
- ラベル
- 500ml滅菌ポリ瓶


13項目検査キットの容器
13項目検査キットの中身は以下。
- 13項目セット 採水マニュアル
- ラベル
- 200ml滅菌ポリ瓶 1本
- 1Lポリ瓶 1本


自宅でお水を採取
レジオネラ検査のお水採取はこんな感じでした。


13項目検査のお水採取はこんな感じでした。
(水道水採取の写真)
検査結果
数日後、検査結果が出ました!
まずはレジオネラ検査から。

レジオネラ検査結果

結果はレジオネラ『陰性』でした。
この結果について、検査課のB課長にレジオネラ対策も含めてコメントしてもらいました。
検査2課のB課長のコメント:
「結果はレジオネラ属菌『陰性』でしたので、問題ないでしょう。
レジオネラ症は、レジオネラ属菌によっておこる病気です。特に、抵抗力の弱い老人や乳幼児に多いといわれています。公衆浴場や温泉などの不特定多数が利用する施設での発生事例が多いのですが、レジオネラ属菌は、一般環境中のどこにでも存在する菌ですので、ご家庭のお風呂などでも、条件により繁殖し、罹患する可能性があります。レジオネラ属菌に汚染された水が、目に見えない非常に細かい粒(エアロゾルといいます)になり、それを吸い込むことにより感染します。人から人へは、感染しません。
さて、レジオネラ属菌は、消毒されていない水や、入れ替わりの少ない水、水温20℃~50℃前後の水に混入した時、増殖するおそれがあると言われています。特に給水・給湯設備、冷却塔水、循環式浴槽、加湿器、水景施設などでレジオネラ属菌が見つかっています。
ご家庭においても、毎日お湯を入れ換えている場合は問題ありませんが、お湯を循環ろ過して長期間使用する、いわゆる24時間風呂の場合はレジオネラ属菌が増殖する可能性があります。お風呂のお湯は適宜取り換え、浴槽の清掃を行い清潔に保ちましょう。さらに、浴槽水のシャワーへの使用や、気泡ジェットなどのエアロゾルを発生する器具の使用も避けたほうが良いと思われます。また、レジオネラ属菌が繁殖する栄養源ともなりますので、浴槽に入る前には、出来るだけ体の汚れを落としてから入るようにしましょう。
循環式浴槽においては、長期間の使用により、循環管路内、特にろ過器内にバイオフィルムと呼ばれる細菌叢が形成されている場合があります。バイオフィルムが存在すると、塩素などの消毒剤が効きにくくなるため、定期的な清掃が必要となる場合があります。
その他ご家庭で注意するものとして、加湿器によるレジオネラ感染があります。加湿器の種類にもよりますが、超音波式などの、ミストが発生するタイプのものでは、加湿器の水を溜めておくタンクの管理が悪いとレジオネラ属菌が増殖し、空気中に飛散することになります。水はこまめに取り換え、使用する水も水道水など衛生的な水を使用しましょう。また、定期的にノズルの清掃やタンクの洗浄を行い、加湿器を使用しない間は水を抜いてきれいにしておきましょう」
水道水検査結果(13項目検査結果)
こちらもB課長に結果について解説を兼ねて聞いてみました。
検査2課のB課長のコメント:
「今回は、一般的に井戸水などの検査で行われる、11項目の検査に追加して、鉄・硬度の検査を行いました。結果は、13項目全てにおいて、水道水質基準を満足しており、問題ないといえるでしょう。
個々の結果について、説明します。
一般細菌、大腸菌・・・一般細菌は、自然界のどこにでも存在するような一般的な細菌類のことです。一部、有害性を持つものもありますが、そのほとんどは無害なもので、これが多いからと言って、直ちに健康影響が出るわけではありません。しかしながら、一般細菌が多いということは、病原生物に汚染されている可能性が上がるということですので、注意が必要です。大腸菌は、人や生物の腸管内に存在しているため、検出された場合は、その水が糞便由来の汚染を受けている可能性が高くなります。水源の種類によっては、クリプトスポリジウム・ジアルジアなどの糞便由来の病原生物に汚染されている可能性もありますので、対応が必要となります。
亜硝酸態窒素、硝酸態窒素・・・窒素の酸化物で、水中の有機性窒素化合物が分解することにより生成されます。起源は様々で、自然界中に普通に存在しますが、畜産排水や工場排水、生活排水等の混入による汚染や、浅井戸では、農用地での肥料の使用により地下浸透し、増加することがあります。亜硝酸態窒素、硝酸態窒素で問題になるのが、亜硝酸態窒素によるメトヘモグロビン血症で、特に乳幼児では、硝酸態窒素が腸内細菌により亜硝酸となり、メトヘモグロビン血症により呼吸作用を阻害することがあるため、注意が必要です。
鉄及びその化合物・・・鉄は、人の栄養に必須元素であり、多量に摂取しなければ特に問題はありません。しかしながら、高濃度になると不快な臭味を与え、酸化した鉄により、布地や器物などを赤褐色に着色する場合があります。
塩化物イオン・・・自然界に広く存在し、多量に摂取しても特に問題はありませんが、塩臭味を引き起こすことになります。
カルシウム、マグネシウム等(硬度)・・・主として地質に由来します。人の健康に有害な影響を与えることはありませんが、あまりに硬度が高い水を飲むと、胃腸障害を起こすことがあります。硬度を多く含む水を硬水、少ない水を軟水と言います。数値が低いと癖のない味となり、高いと好き嫌いが出ます。いわゆるおいしい水の要件としては、硬度が10~100mg/L程度と言われています。硬度が高いと、石鹸の泡立ちに影響を与えますし、給湯器などの配管へのスケール付着の原因にもなります。
pH値・・・水の酸性あるいはアルカリ性の強さを表します。中性はpH7で、数値が大きくなるほどアルカリ性が強くなり、小さくなるほど酸性が強くなります。水道設備や配水管への腐食性に関係しています。基準値内では、特に問題はありませんが、極端に高い(または低い)場合は、目・皮膚・粘膜などに影響を与えることがあります。
味、臭気・・・水質基準では無味無臭である必要があります。但し、水道水においては、塩素添加による滅菌処理が義務付けられていますので、塩素臭味がすることがあります。仮に、異常な臭味がした場合は、何らかの汚染を受けている可能性がありますので、直ちに水道局や水道管理者に連絡する必要があります。
色度、濁度・・・水の色や濁りの程度を表します。水質基準では、ほとんど無色透明であることとなっています。色度については、主として地質に由来するフミン質によるもので、工場排水や下水等の混入または酸化した鉄分などによる着色もあります。濁度は、土壌その他浮遊物質の混入、溶存物質の化学的変化などによるものがほとんどです。濁度については、濁度成分そのものより、濁度以外の水質項目に関連していたり、影響を与えたりすることがあるため、注意が必要となります。
総合コメント:今回の結果は、お風呂の水、飲料水共に問題のない結果でしたが、水質は、変化していきます。今後も定期的な検査をすることをお勧めします」
検査を終えたA社員の感想
A社員からの感想は以下です。
『検査会社にいながら自宅の検査は初めてでしたが、手軽に検査できました。お風呂の水も水道水も水質に問題ないということで安心しました。お風呂は子供とコミニケーションが取れる大切な時間なので、今では安心してその時間を過ごせています。また、キッチンの水は家族の食事の一部、体の一部になるので、問題ないということで安心しました』

まとめ
以上、水質検査レポートでした。
いろんな悩みで自宅の水が気になっている方は多いと思います。水質検査はこんな感じで手軽に検査できるので、是非ご検討ください(弊社の水質検査は『環境未来株式会社HP』からどうぞ)。
